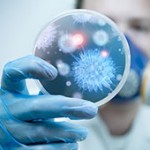

Статьи
В курсе лечения: мифы и правда про антибиотики
Открытие антибиотиков стало главным достижением медицины за последнее столетие. Благодаря им люди практически забыли о дифтерии, тифе, сифилисе, коклюше и других опасных заболеваниях. Но,...
Бактериальный апокалипсис: действительно ли вам нужно принимать антибиотики?
Исследование ученых из университета Мэриленда (США) показывало: из 506 случаев, когда врачи выписывали антибиотики, оправданы были только 353. В остальных случаях больные с таким...
Рост употребления антибиотиков угрожает здоровью жителей Земли
Именно к такому неутешительному выводу пришли члены международной группы исследователей. Результаты их работы были опубликованы в американском специализированном журнале Proceedings of the National Academy...
У вас в носу живет смертельная бактерия! А вы и не знали!
Ученые обнаружили опасный микроорганизм, который затаился у вас в ноздрях. Авторы обследовали 12 здоровых добровольцев и выяснили, что глубокие отделы полости носа (которые обычно не...
Инфекции могут сделать вас глупым! Как не заболеть?
Эксперты считают, что патологическая активность ряда распространенных микробов может приводить к проблемам с памятью. Ученые из университета Майами (штат Флорида, США) и Колумбийского университета (штат...
Бактерии управляют вашим настроением
Последние исследования однозначно свидетельствуют в пользу того, что мозг и пищеварительный тракт неразрывно связаны: диета и кишечные бактерии способны влиять на наше поведение, мысли...
Воспаленное ухо? Что лучше: таблетки или растворы?
С наружным отитом сталкивался каждый из нас. Поплавали в холодной речке или прошлись без шапки под пронизывающим ветром – и вот вы уже счастливый...